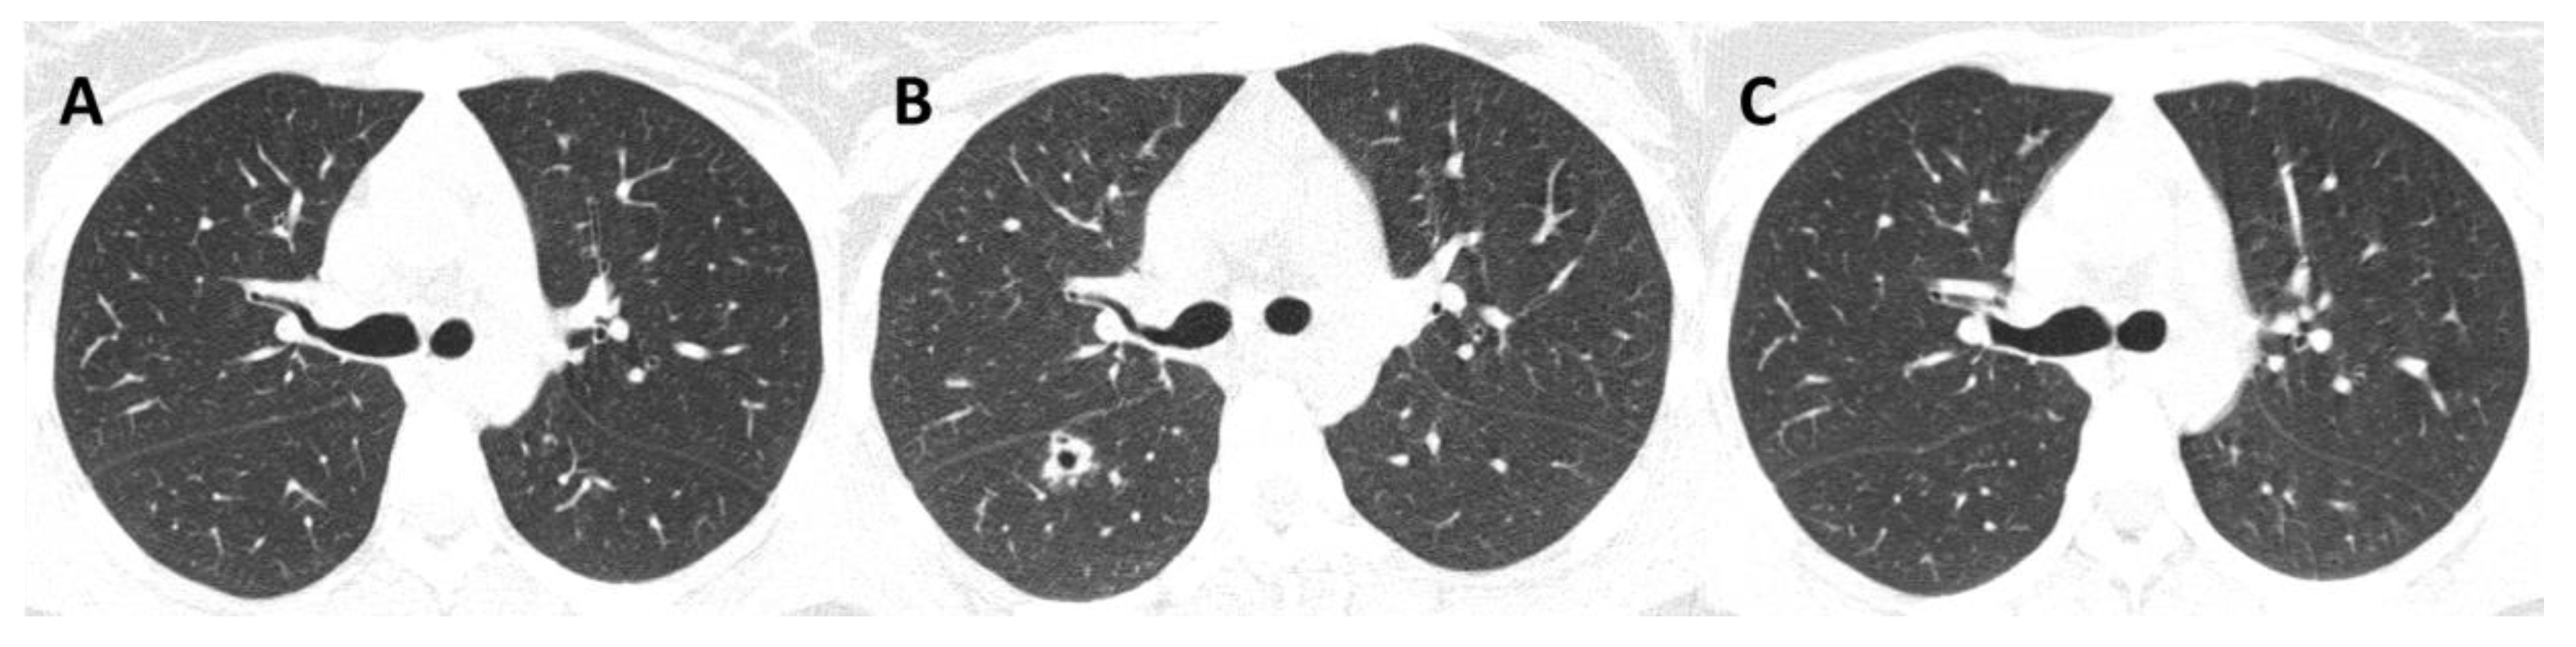
Jof 08 00536 g003 550

Pulmonary Sporotrichosis Caused by Sporothrix brasiliensis: A 22-Year, Single-Center, Retrospective Cohort Study
Abstract
:1. Introduction
2. Materials and Methods
2.1. Study Design
2.2. Clinical Management
2.3. Laboratory Methods
2.4. Treatment
2.5. Data Analyses
2.6. Literature Search
3. Results
3.1. Laboratory Data
3.2. Patient Data
3.3. Radiological Patterns
3.4. Treatment Response and Outcomes
3.5. Brazilian Cases of Pulmonary Sporotrichosis from Zoonotic Transmission
4. Discussion
5. Conclusions
Author Contributions
Funding
Institutional Review Board Statement
Informed Consent Statement
Data Availability Statement
Conflicts of Interest
References
- de Lima Barros, M.B.; de Almeida Paes, R.; Schubach, A.O. Sporothrix schenckii and sporotrichosis. Clin. Microbiol. Rev. 2011, 24, 354–633. [Google Scholar] [CrossRef] [Green Version]
- Orofino-Costa, R.; Rodrigues, A.M.; de Macedo, P.M.; Bernardes-Engemann, A.R. Sporotrichosis: An update on epidemiology, etiopathogenesis, laboratory and clinical therapeutics. An. Bras. Dermatol. 2017, 92, 606–620. [Google Scholar] [CrossRef]
- Freitas, D.F.S.; Valle, A.C.F.D.; da Silva, M.B.T.; Campos, D.P.; Lyra, M.R.; de Souza, R.V.; Veloso, V.G.; Zancopé-Oliveira, R.M.; Bastos, F.I.; Galhardo, M.C.G. Sporotrichosis: An emerging neglected opportunistic infection in HIV-infected patients in Rio de Janeiro, Brazil. PLoS Negl. Trop. Dis. 2014, 8, e3110. [Google Scholar] [CrossRef]
- De Lima Barros, M.B.; De Oliveira Schubach, A.; Francesconi Do Valle, A.C.; Gutierrez Galhardo, M.C.; Conceição-Silva, F.; Pacheco Schubach, T.M.; Santos Reis, R.; Wanke, B.; Feldman Marzochi, K.B.; Conceição, M.J. Cat-Transmitted Sporotrichosis Epidemic in Rio de Janeiro, Brazil: Description of a Series of Cases. Clin. Infect. Dis. 2004, 38, 529–535. [Google Scholar] [CrossRef] [Green Version]
- Ramos, V.; Astacio, G.S.M.; Do Valle, A.C.F.; de Macedo, P.M.; Lyra, M.R.; Almeida-Paes, R.; Oliveira, M.M.E.; Zancopé-Oliveira, R.M.; Brandão, L.G.P.; Quintana, M.S.B.; et al. Bone sporotrichosis: 41 cases from a reference hospital in Rio de Janeiro, Brazil. PLoS Negl. Trop. Dis. 2021, 15, e0009250. [Google Scholar] [CrossRef]
- Almeida-Paes, R.; de Oliveira, M.M.E.; Freitas, D.F.S.; do Valle, A.C.F.; Zancopé-Oliveira, R.M.; Gutierrez-Galhardo, M.C. Sporotrichosis in Rio de Janeiro, Brazil: Sporothrix brasiliensis Is Associated with Atypical Clinical Presentations. PLoS Negl. Trop. Dis. 2014, 8, e3094. [Google Scholar] [CrossRef] [Green Version]
- Freitas, D.F.S.; Lima, M.A.; De Almeida-Paes, R.; Lamas, C.C.; Do Valle, A.C.F.; Oliveira, M.M.E.; Zancop-Oliveira, R.M.; Gutierrez-Galhardo, M.C. Sporotrichosis in the Central Nervous System Caused by Sporothrix brasiliensis. Clin. Infect. Dis. 2015, 61, 663–664. [Google Scholar] [CrossRef] [Green Version]
- Etchecopaz, A.; Toscanini, M.A.; Gisbert, A.; Mas, J.; Scarpa, M.; Iovannitti, C.A.; Bendezú, K.; Nusblat, A.D.; Iachini, R.; Cuestas, M.L. Sporothrix brasiliensis: A review of an emerging south american fungal pathogen, its related disease, presentation and spread in Argentina. J. Fungi 2021, 7, 170. [Google Scholar] [CrossRef]
- Aung, A.K.; Teh, B.M.; McGrath, C.; Thompson, P.J. Pulmonary sporotrichosis: Case series and systematic analysis of literature on clinico-radiological patterns and management outcomes. Med. Mycol. 2013, 51, 534–544. [Google Scholar] [CrossRef] [Green Version]
- Comstock, C.; Wolson, A.H. Roentgenology of sporotrichosis. Am. J. Roentgenol. Radium Ther. Nucl. Med. 1975, 125, 651–655. [Google Scholar] [CrossRef]
- Kauffman, C.A.; Bustamante, B.; Chapman, S.W.; Pappas, P.G. Clinical Practice Guidelines for the Management of Sporotrichosis: 2007 Update by the Infectious Diseases Society of America. Clin. Infect. Dis. 2007, 45, 1255–1265. [Google Scholar] [CrossRef] [Green Version]
- Falcão, E.M.M.; De Lima Filho, J.B.; Campos, D.P.; Do Valle, A.C.F.; Bastos, F.I.; Gutierrez-Galhardo, M.C.; Freitas, D.F.S. Hospitalizations and deaths related to sporotrichosis in Brazil (1992–2015). Cad. Saude Publica 2019, 35, e00109218. [Google Scholar] [CrossRef] [Green Version]
- Freitas, D.F.S.; De Siqueira Hoagland, B.; Do Valle, A.C.F.; Fraga, B.B.; De Barros, M.B.; De Oliveira Schubach, A.; De Almeida-Paes, R.; Cuzzi, T.; Rosalino, C.M.V.; Zancopé-Oliveira, R.M.; et al. Sporotrichosis in HIV-infected patients: Report of 21 cases of endemic sporotrichosis in Rio de Janeiro, Brazil. Med. Mycol. 2012, 50, 170–178. [Google Scholar] [CrossRef] [Green Version]
- de Oliveira, L.C.; Almeida-Paes, R.; Pizzini, C.V.; Gutierrez-Galhardo, M.C.; Freitas, D.F.S.; Zancopé-Oliveira, R.M. Diagnostic performance of mycologic and serologic methods in a cohort of patients with suspected sporotrichosis. Rev. Iberoam. Micol. 2019, 36, 61–65. [Google Scholar] [CrossRef]
- Rodrigues, A.M.; de Hoog, G.S.; de Camargo, Z.P. Molecular Diagnosis of Pathogenic Sporothrix Species. PLoS Negl. Trop. Dis. 2015, 9, e0004190. [Google Scholar] [CrossRef] [Green Version]
- Francesconi, G.; Carlos Francesconi do Valle, A.; Lambert Passos, S.; Bastos de Lima Barros, M.; de Almeida Paes, R.; Luiz Land Curi, A.; Liporage, J.; Ferreira Porto, C.; Clara Gutierrez Galhardo, M.; Passos, S.L.; et al. Comparative Study of 250 mg/day Terbinafine and 100 mg/day Itraconazole for the Treatment of Cutaneous Sporotrichosis. Mycopathologia 2011, 171, 349–354. [Google Scholar] [CrossRef]
- Paixão, A.G.; Galhardo, M.C.G.; Almeida-Paes, R.; Nunes, E.P.; Gonçalves, M.L.C.; Chequer, G.L.; Lamas, C.D.C. The difficult management of disseminated Sporothrix brasiliensis in a patient with advanced AIDS. AIDS Res. Ther. 2015, 12, 1–6. [Google Scholar] [CrossRef] [Green Version]
- Ferreira, T.A.; Trope, B.M.; Barreiros, G.; Quintela, D.C.; Ramos-E-Silva, M. Atypical manifestation of disseminated sporotrichosis in an AIDS patient. Case Rep. Dermatol. 2018, 10, 231–237. [Google Scholar] [CrossRef]
- Orofino-Costa, R.; Unterstell, N.; Carlos Gripp, A.; De Macedo, P.M.; Brota, A.; Dias, E.; De Melo Teixeira, M.; Felipe, M.S.; Bernardes-Engemann, A.R.; Lopes-Bezerra, L.M. Pulmonary cavitation and skin lesions mimicking tuberculosis in a HIV negative patient caused by Sporothrix brasiliensis. Med. Mycol. Case Rep. 2013, 2, 65–71. [Google Scholar] [CrossRef]
- de Oliveira-Esteves, I.C.M.R.; Almeida Rosa da Silva, G.; Eyer-Silva, W.D.A.; Basílio-de-Oliveira, R.P.; de Araujo, L.F.; Martins, C.J.; Neves-Motta, R.; Velho Mendes de Azevedo, M.C.; Signorini, D.J.H.P.; Francisco da Cunha Pinto, J.; et al. Rapidly Progressive Disseminated Sporotrichosis as the First Presentation of HIV Infection in a Patient with a Very Low CD4 Cell Count. Case Rep. Infect. Dis. 2017, 2017, 1–5. [Google Scholar] [CrossRef] [Green Version]
- Barros, N.D.M.; Pessoa, A.D.S.; Brotas, A.M. Systemic sporotrichosis in an alcoholic patient. An. Bras. Dermatol. 2020, 95, 376–378. [Google Scholar] [CrossRef]
- Alves, M.D.M.; Milan, E.P.; da Silva-Rocha, W.P.; da Costa, A.S.D.S.; Maciel, B.A.; Vale, P.H.C.; de Albuquerque, P.R.; Lima, S.L.; Melo, A.S.D.A.; Rodrigues, A.M.; et al. Fatal pulmonary sporotrichosis caused by Sporothrix brasiliensis in Northeast Brazil. PLoS Negl. Trop. Dis. 2020, 14, e0008141. [Google Scholar] [CrossRef]
- Rappleye, C.A.; Goldman, W.E. Defining virulence genes in the dimorphic fungi. Annu. Rev. Microbiol. 2006, 60, 281–303. [Google Scholar] [CrossRef]
- Quintal, D. Sporotrichosis infection on mines of the Witwatersrand. J. Cutan. Med. Surg. 2000, 4, 51–54. [Google Scholar] [CrossRef]
- Sethi, K.K.; Kneipp, V.L.; Schwarz, J. Pulmonary sporotrichosis in mice following intranasal infection. Am. Rev. Respir. Dis. 1966, 93, 463–464. [Google Scholar] [CrossRef]
- Conti-Díaz, I.A.; Civila, E. Exposure of mice to inhalation of pigmented conidia of Sporothrix schenckii. Mycopathol. Mycol. Appl. 1969, 38, 1–6. [Google Scholar] [CrossRef]
- Falcão, E.M.M.; Pires, M.C.D.S.; Andrade, H.B.; Gonçalves, M.L.C.; Almeida-Paes, R.; Do Valle, A.C.F.; Bastos, F.I.; Gutierrez-Galhardo, M.C.; Freitas, D.F.S. Zoonotic sporotrichosis with greater severity in Rio de Janeiro, Brazil: 118 hospitalizations and 11 deaths in the last 2 decades in a reference institution. Med. Mycol. 2020, 58, 141–143. [Google Scholar] [CrossRef]
- Arinelli, A.; Aleixo, A.L.Q.C.Q.C.; Freitas, D.F.S.S.; do Valle, A.C.F.F.; Almeida-Paes, R.; Nobre Guimarães, A.L.; Oliveira, R.V.C.C.; Gutierrez-Galhardo, M.C.; Curi, A.L.L.L. Ocular Manifestations of Sporotrichosis in a Hyperendemic Region in Brazil: Description of a Series of 120 Cases. Ocul. Immunol. Inflamm. 2022, 1–9. [Google Scholar] [CrossRef]
- Gremião, I.D.F.; Martins da Silva da Rocha, E.; Montenegro, H.; Carneiro, A.J.B.; Xavier, M.O.; de Farias, M.R.; Monti, F.; Mansho, W.; de Macedo Assunção Pereira, R.H.; Pereira, S.A.; et al. Guideline for the management of feline sporotrichosis caused by Sporothrix brasiliensis and literature revision. Braz. J. Microbiol. 2021, 52, 107–124. [Google Scholar] [CrossRef]
- Schubach, T.M.P.; Schubach, A.; Okamoto, T.; Barros, M.B.L.; Figueiredo, F.B.; Cuzzi, T.; Fialho-Monteiro, P.C.; Reis, R.S.; Perez, M.A.; Wanke, B. Evaluation of an epidemic of sporotrichosis in cats: 347 cases (1998–2001). J. Am. Vet. Med. Assoc. 2004, 224, 1623–1629. [Google Scholar] [CrossRef]
- Tachibana, T.; Matsuyama, T.; Mitsuyama, M. Involvement of CD4+ T cells and macrophages in acquired protection against infection with Sporothrix schenckii in mice. Med. Mycol. 1999, 37, 397–404. [Google Scholar] [CrossRef] [PubMed] [Green Version]
- Garcia, L.P.; de Freitas, L.R.S. Heavy drinking in Brazil: Results from the 2013 National Health Survey Heavy drinking in Brazil. Epidemiol. E Serviços Saúde 2015, 24, 227–237. [Google Scholar] [CrossRef]
- Pasala, S.; Barr, T.; Messaoudi, I. Impact of Alcohol Abuse on the Adaptive Immune System. Alcohol Res. 2015, 37, 185–197. [Google Scholar] [PubMed]
- Pluss, J.L.; Opal, S.M. Pulmonary sporotrichosis: Review of treatment and outcome. Medicine 1986, 65, 143–153. [Google Scholar] [CrossRef]
- Benedict, K.; Jackson, B.R. Sporotrichosis Cases in Commercial Insurance Data, United States, 2012–2018. Emerg. Infect. Dis. 2020, 26, 2783. [Google Scholar] [CrossRef]
- Lowenstein, M.; Markowitz, S.M.; Nottebart, H.C.; Shadomy, S. Existence of Sporothrix schenckii as a pulmonary saprophyte. Chest 1978, 73, 419–421. [Google Scholar] [CrossRef]
- Aung, A.K.; Spelman, D.W.; Thompson, P.J. Pulmonary Sporotrichosis: An Evolving Clinical Paradigm. Semin. Respir. Crit. Care Med. 2015, 36, 756–766. [Google Scholar] [CrossRef]

| Case (Year) 1 | Sex | Age | Risk Exposure | Clinical Presentation | Organs and Systems Affected | Comorbidities/ Immunosuppression 2 | Other Coinfections | Radiological Findings | Pulmonary Positive Culture Specimen | Treatment | Outcome |
|---|---|---|---|---|---|---|---|---|---|---|---|
| 1 (2018) | Male | 71 | None | Primary pulmonary | Lungs | Alcoholism COPD | No | Reticulonodular infiltrate; cavitation; fibrosis Unilateral/Multilobar | Sputum; BAL | ITZ; PSZ | Under treatment |
| 2 (2018) | Male | 63 | Contact with cat | Disseminated | Lungs, bone | Alcoholism COPD | No | Cavitation; fibrosis; hilar lymphadenopathy Unilateral/Unilobar | Sputum; BAL | ITZ; AmB; PSZ | Under treatment |
| 3 (2015) | Male | 52 | Contact with soil/plants | Disseminated | Skin, lungs, bone | HIV (CD4 = 46 cells/mm3) | Sepsis caused by Klebsiella | Nodule without cavitation Unilateral/Unilobar | BAL | ITZ; AmB | Cure |
| 4 (2012) | Male | 25 | Contact with soil/plants | Disseminated | Skin, lungs, bones, upper airways, eyes | HIV (CD4 = 25 cells/mm3) Alcoholism | Tuberculosis | Multiple nodules without cavitation Bilateral/Mulilobar | Sputum; BAL | ITZ; TBF; AmB; PSZ | Death |
| 5 (2015) | Female | 31 | Contact with diseased cats | Disseminated | Skin, bones | HIV (CD4 = 21 cells/mm3) | Pulmonary sepsis caused by Acinetobacter Kaposi’s sarcoma | None | Sputum | ITZ; AmB | Cure |
| 6 (2012) | Female | 20 | Scratched by diseased cat | Disseminated | Skin, bones, CNS | HIV (CD4 = 42 cells/mm3) | No | Multiple Nodules without cavitation Bilateral/Multilobar | Sputum | ITZ; TBF; AmB; PSZ | Death |
| 7 (2007) | Male | 44 | Contact with soil/plants | Disseminated | Skin, bone, CNS | HIV CD4 = 110 cells/mm3) Alcoholism | Tuberculosis | Pleural effusion | Sputum | ITZ; AmB | Death |
| 8 (2008) | Male | 26 | Contact with diseased cat | Disseminated | Skin, upper airways, CNS | HIV (CD4 = 178 cells/mm3) Alcoholism | No | None | Sputum | ITZ; AmB | Death |
| 9 (2011) | Male | 36 | Scratched by diseased cat | Disseminated | Skin, bones, upper airways | HIV (CD4 = 66 cells/mm3) | No | None | Sputum | ITZ; TBF; AmB | Loss of follow-up |
| 10 (2019) | Male | 46 | Bitten by diseased cat | Disseminated | Skin, bones, upper airways | HIV (CD4 = 35 cells/mm3) Alcoholism | No | None | Sputum | ITZ; AmB | Cure |
| 11 (2003) | Male | 18 | Contact with diseased cat and with soil/plants | Disseminated | Skin, bones, upper airways, eyes | Alcoholism | Nocardiosis | Non | Sputum | ITZ; TBF; AmB | Cure |
| 12 (2017) | Male | 35 | Contact with diseased cat (sneezing) and with soil/plants | Disseminated | Skin, bones, upper airways, CNS, eyes | HIV (CD4 = 75 cells/mm3) Alcoholism | Tuberculosis | None | Sputum | ITZ; AmB | Death |
| 13 (2013) | Male | 43 | Scratched by diseased cat | Disseminated | Skin, bones, upper airways | HIV (CD4 = 35 cells/mm3) Alcoholism | Tuberculosis | Diffuse reticulonodular infiltrate; calcified nodules, fibrosis | Sputum | ITZ; TBF; AmB; PSZ | Death |
| 14 (2018) | Female | 20 | Contact with diseased cats | Disseminated | Skin, lungs, bones, upper airways | HIV (CD4 = 56 cells/mm3) Alcoholism | Pneumocystis pneumonia | Cavitation; reticulonodular infiltrate; consolidation | Sputum | ITZ; AmB; PSZ | Cure |
Publisher’s Note: MDPI stays neutral with regard to jurisdictional claims in published maps and institutional affiliations. |
© 2022 by the authors. Licensee MDPI, Basel, Switzerland. This article is an open access article distributed under the terms and conditions of the Creative Commons Attribution (CC BY) license (https://creativecommons.org/licenses/by/4.0/).
Share and Cite
Fichman, V.; Mota-Damasceno, C.G.; Procópio-Azevedo, A.C.; Almeida-Silva, F.; de Macedo, P.M.; Medeiros, D.M.; Astacio, G.S.-M.; Zancopé-Oliveira, R.M.; Almeida-Paes, R.; Freitas, D.F.S.; et al. Pulmonary Sporotrichosis Caused by Sporothrix brasiliensis: A 22-Year, Single-Center, Retrospective Cohort Study. J. Fungi 2022, 8, 536. https://doi.org/10.3390/jof8050536
Fichman V, Mota-Damasceno CG, Procópio-Azevedo AC, Almeida-Silva F, de Macedo PM, Medeiros DM, Astacio GS-M, Zancopé-Oliveira RM, Almeida-Paes R, Freitas DFS, et al. Pulmonary Sporotrichosis Caused by Sporothrix brasiliensis: A 22-Year, Single-Center, Retrospective Cohort Study. Journal of Fungi. 2022; 8(5):536. https://doi.org/10.3390/jof8050536
Chicago/Turabian StyleFichman, Vivian, Caroline Graça Mota-Damasceno, Anna Carolina Procópio-Azevedo, Fernando Almeida-Silva, Priscila Marques de Macedo, Denise Machado Medeiros, Guis Saint-Martin Astacio, Rosely Maria Zancopé-Oliveira, Rodrigo Almeida-Paes, Dayvison Francis Saraiva Freitas, and et al. 2022. "Pulmonary Sporotrichosis Caused by Sporothrix brasiliensis: A 22-Year, Single-Center, Retrospective Cohort Study" Journal of Fungi 8, no. 5: 536. https://doi.org/10.3390/jof8050536
APA StyleFichman, V., Mota-Damasceno, C. G., Procópio-Azevedo, A. C., Almeida-Silva, F., de Macedo, P. M., Medeiros, D. M., Astacio, G. S.-M., Zancopé-Oliveira, R. M., Almeida-Paes, R., Freitas, D. F. S., & Gutierrez-Galhardo, M. C. (2022). Pulmonary Sporotrichosis Caused by Sporothrix brasiliensis: A 22-Year, Single-Center, Retrospective Cohort Study. Journal of Fungi, 8(5), 536. https://doi.org/10.3390/jof8050536

